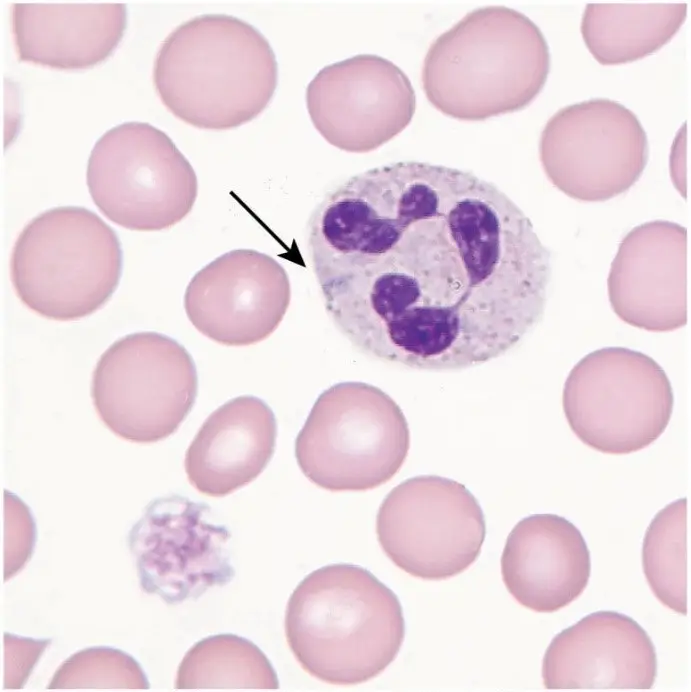
圖片

109年:(醫檢)血液(1)
病人血小板數目 5,000/μL , MPV 20fL (正常值 10 ~ 13fL ),其血液抹片如下圖。下列敘述何者最正確?
A箭頭所指為 Döhle body ,最可能診斷MYH9 related disease
B箭頭所指為 Auer rod ,最可能診斷 acute myeloid leukemia
C箭頭所指為 toxic granule ,最可能診斷 bacterial infection ( septic shock )
D箭頭所指為 Barr body ,最可能診斷MYH9 related disease
詳細解析
本題觀念:
本題考核 MYH9 相關疾病(MYH9-related disease, MYH9-RD)的血液抹片特徵,以及如何與其他含有嗜中性白血球內含物的疾病做鑑別診斷。MYH9-RD 是一種體染色體顯性遺傳疾病,由編碼非肌肉型肌凝蛋白 IIA(non-muscle myosin IIA)重鏈的 MYH9 基因突變所致,其三大特徵為:巨大血小板(giant platelets)、血小板低下(thrombocytopenia)及嗜中性球內含物(neutrophil inclusions,形似 Döhle bodies)。
影像分析:
血液抹片(Wright-Giemsa 染色)可見以下特徵:
- 中央白血球:視野中央可見一顆多葉核(multilobed nucleus)嗜中性球,核葉呈深紫色,胞質淡染。
- 箭頭所指之內含物:箭頭指向嗜中性球胞質中一個呈淡藍灰色(pale basophilic)的內含物,形態呈不規則橢圓形,邊界清晰。此即 Döhle body-like inclusion(MYH9-RD 特徵性異常非肌肉型肌凝蛋白 IIA 聚集體)。
- 視野左下角:可見一顆明顯巨大的血小板(giant platelet),其大小接近或超過紅血球直徑的一半,與病人 MPV 高達 20 fL(正常 10–13 fL)相符。
-
...(解析預覽)...

升級 VIP 解鎖圖文解析